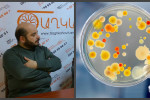

Դեպքեր
 «Ադրբեջանը ունի առավելություն. այնտեղ շեշտը դրվում է տեխնլոգիաների վրա»
«Ադրբեջանը ունի առավելություն. այնտեղ շեշտը դրվում է տեխնլոգիաների վրա»
 Խոշոր ավտովթար Արարատի մարզում
Խոշոր ավտովթար Արարատի մարզում
 Դարձել ենք 1-ին դասարանցու ամուսնալուծված ծնողների հարաբերությունների մատաղացուն. դպրոցի տնօրենը՝ սկանդալի մասին
Դարձել ենք 1-ին դասարանցու ամուսնալուծված ծնողների հարաբերությունների մատաղացուն. դպրոցի տնօրենը՝ սկանդալի մասին
 Ֆիլիպինների նախագահը երգում է Թրամփի պատվերով (տեսանյութ)
Ֆիլիպինների նախագահը երգում է Թրամփի պատվերով (տեսանյութ)
 «Եվրոպայի ժողովրդավարական ճգնաժամը. ծնվում են ռասիզմը, ֆաշիզմը...». Լևոն Շիրինյան (video)
«Եվրոպայի ժողովրդավարական ճգնաժամը. ծնվում են ռասիզմը, ֆաշիզմը...». Լևոն Շիրինյան (video)
 Մեկնարկել է ռուս-ադրբեջանական «Սահման-արգելապատնեշ» գործողությունը
Մեկնարկել է ռուս-ադրբեջանական «Սահման-արգելապատնեշ» գործողությունը
 Էրիվանի խանության ժամանակները. Վանո Սիրադեղյանը 71 տարեկան է
Էրիվանի խանության ժամանակները. Վանո Սիրադեղյանը 71 տարեկան է
 Այսօր Վանո Սիրադեղյանի ծննդյան օրն է. բացառիկ տեսանյութ
Այսօր Վանո Սիրադեղյանի ծննդյան օրն է. բացառիկ տեսանյութ
 ՊՆ-ն բացատրում է, թե ինչու է Վիգեն Սարգսյանի բանակում ծառայության գործը ոչնչացվել
ՊՆ-ն բացատրում է, թե ինչու է Վիգեն Սարգսյանի բանակում ծառայության գործը ոչնչացվել
 Տեսանյութ Իրանում տեղի ունեցած երկրաշարժից
Տեսանյութ Իրանում տեղի ունեցած երկրաշարժից
 «Տաշիր»-ը 1 մլրդ դոլարի ներդրում կանի
«Տաշիր»-ը 1 մլրդ դոլարի ներդրում կանի
 Ոստիկանությունը հրապարակել է հոշոտված հայտնաբերված կնոջ հագուստի լուսանկարները և ճանաչողներին խնդրում է արձագանքել (լուսանկարներ)
Ոստիկանությունը հրապարակել է հոշոտված հայտնաբերված կնոջ հագուստի լուսանկարները և ճանաչողներին խնդրում է արձագանքել (լուսանկարներ)
 Սկանդալ Երևանի Ջոն Կիրակոսյանի անվան դպրոցում. 1-ին դասարանի տղայի ձեռքերը սկոտչով կապել են, տարել զուգարան, ծեծի ենթարկել ու կտրել թարթիչները
Սկանդալ Երևանի Ջոն Կիրակոսյանի անվան դպրոցում. 1-ին դասարանի տղայի ձեռքերը սկոտչով կապել են, տարել զուգարան, ծեծի ենթարկել ու կտրել թարթիչները
 Իրանի քաղաքացին փորձել է նռնականետի համալրող սարք անցկացնել ՀՀ սահմանով
Իրանի քաղաքացին փորձել է նռնականետի համալրող սարք անցկացնել ՀՀ սահմանով
 27-ամյա աղջիկ է դանակահարվել
27-ամյա աղջիկ է դանակահարվել
 Դեսանտ Սալոնիկում. Քաղաքում պետական գաղտնիքը առաջինը լրբերը իմացան.Վանո Սիրադեղյան
Դեսանտ Սալոնիկում. Քաղաքում պետական գաղտնիքը առաջինը լրբերը իմացան.Վանո Սիրադեղյան
 «Սուրբ Աստվածամայր» ԲԿ-ում 5 տարեկան երեխա է մահացել. tert.am
«Սուրբ Աստվածամայր» ԲԿ-ում 5 տարեկան երեխա է մահացել. tert.am
 Լիբանանցիները պահանջում են վարչապետ Սաադ Հարիրիի վերադարձը
Լիբանանցիները պահանջում են վարչապետ Սաադ Հարիրիի վերադարձը
 Իրանում երկրաշարժի զոհերի թիվը հասել է 339-ի
Իրանում երկրաշարժի զոհերի թիվը հասել է 339-ի
 Թուրքիան Ռուսաստանից S-400-ներ է գնել
Թուրքիան Ռուսաստանից S-400-ներ է գնել
 Վանո Սիրադեղյան. «Ազգին չկպչենք»
Վանո Սիրադեղյան. «Ազգին չկպչենք»
 Մեդվեդևը ՝ ԵԱՏՄ-ի շահագրգռվածության մասին
Մեդվեդևը ՝ ԵԱՏՄ-ի շահագրգռվածության մասին
 Ինչպե՞ս կարող է Սամվել Բաբայանը չտարբերակել ռազմամթերքն ու անպիտան խողովակը
Ինչպե՞ս կարող է Սամվել Բաբայանը չտարբերակել ռազմամթերքն ու անպիտան խողովակը
 Հայտնաբերված դիակի ինքնությունը չի պարզվել
Հայտնաբերված դիակի ինքնությունը չի պարզվել
 «ՌԴ-ում սեռավարակների տարածվածությունը տասն անգամ գերազանցում է ՀՀ-ին.հայերը հիմնականում մեկնում են ՌԴ».Հովհաննես Հովհաննիսյան (սեռավարակաբան-մաշկաբան) (video)
«ՌԴ-ում սեռավարակների տարածվածությունը տասն անգամ գերազանցում է ՀՀ-ին.հայերը հիմնականում մեկնում են ՌԴ».Հովհաննես Հովհաննիսյան (սեռավարակաբան-մաշկաբան) (video)
 «Ունենք մոտ 40 բուհ, 50 քոլեջ,100-ից ավել ուսումնարան.մասնագետներ ենք պատրաստում Ռուսաստանի համար». Ահարոն Ադիբեկյան (video)
«Ունենք մոտ 40 բուհ, 50 քոլեջ,100-ից ավել ուսումնարան.մասնագետներ ենք պատրաստում Ռուսաստանի համար». Ահարոն Ադիբեկյան (video)
 «Հրամանատարն ասաց՝ մեր տղերքը հրաշալի կրակում են, բայց հրամայես կրակել դպրոցի վրա, չեն ենթարկվի».Լևոն Շիրինյան (video)
«Հրամանատարն ասաց՝ մեր տղերքը հրաշալի կրակում են, բայց հրամայես կրակել դպրոցի վրա, չեն ենթարկվի».Լևոն Շիրինյան (video)
 Իրանի երկրաշարժի հետևանքով զոհերի թիվը հասել է 328-ի
Իրանի երկրաշարժի հետևանքով զոհերի թիվը հասել է 328-ի
 Նիկոլ Փաշինյանին Վիգեն Սարգսյանի տարկետման հիմքերը չեն տրամադրվել. դրանք ոչնչացված են
Նիկոլ Փաշինյանին Վիգեն Սարգսյանի տարկետման հիմքերը չեն տրամադրվել. դրանք ոչնչացված են
 Թուրքիայի վարչապետը դատի է տվել ընդդիմադիր թերթին. պաշտպանում է որդիներին
Թուրքիայի վարչապետը դատի է տվել ընդդիմադիր թերթին. պաշտպանում է որդիներին
Լրահոս
 Սևանի գերեզմանատանը երիտասարդ տղայի մարմին է հայտնաբերվել
Սևանի գերեզմանատանը երիտասարդ տղայի մարմին է հայտնաբերվել
 Դատավորների ընդհանուր ժողովն ընտրել է Էթիկայի և կարգապահական հարցերի հանձնաժողովի նոր անդամների
Դատավորների ընդհանուր ժողովն ընտրել է Էթիկայի և կարգապահական հարցերի հանձնաժողովի նոր անդամների
 Այդ քննարկումներն ինձ ստիպեցին ավելի խորությամբ վերլուծել իրավիճակը. Մելիքյան
Այդ քննարկումներն ինձ ստիպեցին ավելի խորությամբ վերլուծել իրավիճակը. Մելիքյան
 Չկա մի նահատակ, որ նահատակվել է Արցախում, բայց դա չի եղել հանուն Հայաստանի․ Քրիստինե Վարդանյան
Չկա մի նահատակ, որ նահատակվել է Արցախում, բայց դա չի եղել հանուն Հայաստանի․ Քրիստինե Վարդանյան
 Փոստանջյանը դիմել է ՌԴ, ԵՄ և ԱՄՆ դեսպաններին՝ ահազանգելով քաղաքական հետապնդումների մասին
Փոստանջյանը դիմել է ՌԴ, ԵՄ և ԱՄՆ դեսպաններին՝ ահազանգելով քաղաքական հետապնդումների մասին
 Մոջթաբա Խամենեին չի մասնակցի հոր հուղարկավորությանը
Մոջթաբա Խամենեին չի մասնակցի հոր հուղարկավորությանը
 Խոշոր հրդեհ՝ Արմավիրի մարզում․ բակում կայանված «ՎԱԶ 2107»-ը վերածվել է մոխրակույտի
Խոշոր հրդեհ՝ Արմավիրի մարզում․ բակում կայանված «ՎԱԶ 2107»-ը վերածվել է մոխրակույտի
 Գիշերները տաքանում են ավելի արագ, քան ցերեկները՝ մեծացնելով մարդկանց առողջության համար վտանգը
Գիշերները տաքանում են ավելի արագ, քան ցերեկները՝ մեծացնելով մարդկանց առողջության համար վտանգը
 Իրանի ԱԳ նախարարն ու Իրաքի Քուրդիստանի նախագահը քննարկել են տարածաշրջանային վերջին զարգացումները
Իրանի ԱԳ նախարարն ու Իրաքի Քուրդիստանի նախագահը քննարկել են տարածաշրջանային վերջին զարգացումները
 Իսրայելի ավիահարվածների հետևանքով Լիբանանում զոհերի թիվը հասել է 4301-ի
Իսրայելի ավիահարվածների հետևանքով Լիբանանում զոհերի թիվը հասել է 4301-ի
 Երբ ՍԴ-ն կհրապարակի ընտրությունների արդյունքների վերաբերյալ որոշումը
Երբ ՍԴ-ն կհրապարակի ընտրությունների արդյունքների վերաբերյալ որոշումը
 Անդրանիկ Թևանյանը Ալեն Սիմոնյանի դեմ դատական հայց է ներկայացրել
Անդրանիկ Թևանյանը Ալեն Սիմոնյանի դեմ դատական հայց է ներկայացրել
 Սևանի գերեզմանատանը մեքենայում երիտասարդ տղայի մարմին է հայտնաբերվել
Սևանի գերեզմանատանը մեքենայում երիտասարդ տղայի մարմին է հայտնաբերվել
 Պայթյուն՝ Վանաձորի գազալցակայաններից մեկի պահեստային մասում. նախնական տվյալներով՝ կա մեկ տուժած
Պայթյուն՝ Վանաձորի գազալցակայաններից մեկի պահեստային մասում. նախնական տվյալներով՝ կա մեկ տուժած
 Բագրատ սրբազանը դատարանում հաղթել է Անի Խաչատրյանին ու նրա կուսակցին․ «News.5tv.am»
Բագրատ սրբազանը դատարանում հաղթել է Անի Խաչատրյանին ու նրա կուսակցին․ «News.5tv.am»
 Ավտովթար՝ Կոտայքի մարզում. «Lada»-ն բախվել է երկաթե արգելապատնեշին. կան վիրավորներ
Ավտովթար՝ Կոտայքի մարզում. «Lada»-ն բախվել է երկաթե արգելապատնեշին. կան վիրավորներ
 Երևանի խաղահրապարակում վնասված սղարանից երեխա է ընկել
Երևանի խաղահրապարակում վնասված սղարանից երեխա է ընկել
 Իսրայելը հայտարարել է Լիբանանում «Հեզբոլլահ»-ի 10 օբյեկտի հարվածելու մասին
Իսրայելը հայտարարել է Լիբանանում «Հեզբոլլահ»-ի 10 օբյեկտի հարվածելու մասին
 Շինհրապարակներում փոշենստեցման և փոշեճնշիչ միջոցառումները պարտադիր են
Շինհրապարակներում փոշենստեցման և փոշեճնշիչ միջոցառումները պարտադիր են
 #ՀԻՄԱ․ Քաղկալանավայր՝ բաց երկնքի տակ․ ինչ է բուծել Ուրսուլան Հայաստանում․․․ (video)
#ՀԻՄԱ․ Քաղկալանավայր՝ բաց երկնքի տակ․ ինչ է բուծել Ուրսուլան Հայաստանում․․․ (video)
 Նիկո՛լ, լավ էս ինչ խայտառակություն է․ Երվանդ Բոզոյանից ի՞նչ ես ուզում․ Անժելա Թովմասյան (video)
Նիկո՛լ, լավ էս ինչ խայտառակություն է․ Երվանդ Բոզոյանից ի՞նչ ես ուզում․ Անժելա Թովմասյան (video)
 «Ինչու՞ Նիկոլն Ալենին փոխեց Ռուբինյանով»․ Հայկ Նահապետյան (video)
«Ինչու՞ Նիկոլն Ալենին փոխեց Ռուբինյանով»․ Հայկ Նահապետյան (video)
 Պատերազմը հենց Փաշինյանի օրոք է եղել՝ ծախված, միտումնավոր պատերազմ․ Հարցում (video)
Պատերազմը հենց Փաշինյանի օրոք է եղել՝ ծախված, միտումնավոր պատերազմ․ Հարցում (video)
 Աղետալի․ անցած տարի արտահանվել է 50 հազար տոննա ծիրան, այս տարի՝ 8000 տոննա ծիրան չկա Հայաստանում (video)
Աղետալի․ անցած տարի արտահանվել է 50 հազար տոննա ծիրան, այս տարի՝ 8000 տոննա ծիրան չկա Հայաստանում (video)
 Ասեմ՝ ինչ է Բաքվում Ուրսուլա ֆոն դեր Լայենը պայմանավորվել Ալիևի հետ․ Հայկ Նահապետյան (video)
Ասեմ՝ ինչ է Բաքվում Ուրսուլա ֆոն դեր Լայենը պայմանավորվել Ալիևի հետ․ Հայկ Նահապետյան (video)
Ամենաընթերցվածները
 Պուտինը կոպիտ ձևով մերժել է Փաշինյանին (video)
1
Պուտինը կոպիտ ձևով մերժել է Փաշինյանին (video)
1
 Նիկոլը գնում է Ռուսաստան․ էդ ենոքավանցուն ասել են՝ շուստրիությունդ Պուտինի մոտ չի անցնելու․ Մալխասյան (video)
2
Նիկոլը գնում է Ռուսաստան․ էդ ենոքավանցուն ասել են՝ շուստրիությունդ Պուտինի մոտ չի անցնելու․ Մալխասյան (video)
2
 «Ինչու՞ Նիկոլն Ալենին փոխեց Ռուբինյանով»․ Հայկ Նահապետյան (video)
3
«Ինչու՞ Նիկոլն Ալենին փոխեց Ռուբինյանով»․ Հայկ Նահապետյան (video)
3
 Աղետալի․ անցած տարի արտահանվել է 50 հազար տոննա ծիրան, այս տարի՝ 8000 տոննա ծիրան չկա Հայաստանում (video)
4
Աղետալի․ անցած տարի արտահանվել է 50 հազար տոննա ծիրան, այս տարի՝ 8000 տոննա ծիրան չկա Հայաստանում (video)
4
#ՈՒՂԻՂ․ Նիկոլին կարևոր ցուցակից դուրս են թողնում․ ինչ է նախապատրաստում ՌԴ–ն․ Հայկ Նահապետյան (video)
5
#ՈՒՂԻՂ․ Նիկոլին կարևոր ցուցակից դուրս են թողնում․ ինչ է նախապատրաստում ՌԴ–ն․ Հայկ Նահապետյան (video)
5

Շուտով
Հուլիսի 3-ին՝ ժամը 14։00-ին, Հայելի ակումբի հյուրն է Հայկ Նահապետյանը
Հուլիսի 3-ին՝ ժամը 12։00-ին, Հայելի ակումբի հյուրն է Դերենիկ Մալխասյանը
Հուլիսի 3-ին՝ ժամը 15։00-ին, Հայելի ակումբի հյուրն է Արեգա Հովսեփյանը
Հուլիսի 3-ին՝ ժամը 13։00-ին, Հայելի ակումբի հյուրն է Մենուա Սողոմոնյանը
Հուլիսի 3-ին՝ ժամը 16։00-ին, Հայելի ակումբի հյուրն է Հարություն Մնացականյանը
Հուլիսի 2-ին՝ ժամը 16։00-ին, Հայելի ակումբի հյուրն է Հենրիխ Դանիելյանը
Հուլիսի 2-ին՝ ժամը 15։00-ին, Հայելի ակումբի հյուրն է Աննա Այվազյանը
Հուլիսի 2-ին՝ ժամը 12։30-ին, Հայելի ակումբի հյուրն է Արամ Գասպարի Սարգսյանը
Հուլիսի 2-ին՝ ժամը 12։00-ին, Հայելի ակումբի հյուրն է Արման Աբովյանը
Հուլիսի 1-ին՝ ժամը 16։00-ին, Հայելի ակումբի հյուրն է Հենրիխ Դանիելյանը


